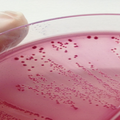

Dupla da UFMG vence competição internacional de ginástica aeróbica
Lucas e Barbosa e Tamires Silva integram projeto coordenado pela professora Kátia Lemos Foto: Acervo de Kátia Lemos | UFMG Tamires Silva e Lucas Barbosa, atletas da ginástica aeróbica da Escola de...